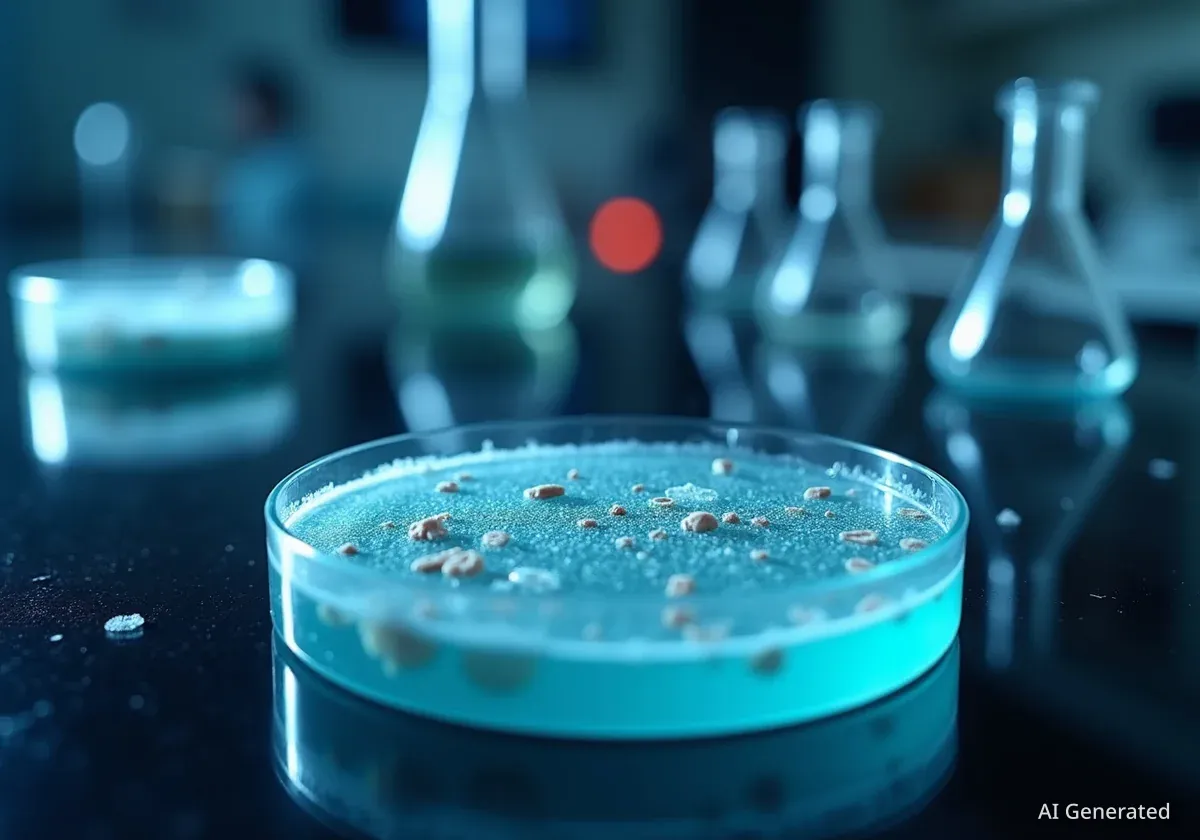
Zuckergel zeigt in Studie Potenzial gegen Haarausfall

KI-Startup sichert sich 300 Millionen für Materialforschung
Ein neues KI-Startup von ehemaligen Forschern von OpenAI und Google hat 300 Millionen US-Dollar erhalten, um die Entdeckung neuer Materialien zu revolutionieren.
15 articles tagged

Ein neues KI-Startup von ehemaligen Forschern von OpenAI und Google hat 300 Millionen US-Dollar erhalten, um die Entdeckung neuer Materialien zu revolutionieren.

Der Nikon Small World Wettbewerb prämiert die besten Mikroskop-Fotos. Ein Bild eines Reiskäfers gewinnt den ersten Preis, gefolgt von deutschen Fotografen.

In Texas ermöglicht Starfront Observatories über 550 Hobby-Astronomen die Fernsteuerung ihrer Teleskope. Die Anlage bietet ideale Bedingungen ohne Lichtverschmutzung.

Eine neue Studie zeigt, dass Wissenschaftler zunehmend das Vertrauen in künstliche Intelligenz verlieren, obwohl sie die Technologie häufiger nutzen.

Ein Projekt an der Cambridge University Library kämpft gegen die Zeit, um historisch wertvolle Daten von alten Disketten zu retten, darunter auch Dateien des Physikers Stephen Hawking.
Forscher haben entdeckt, dass ein Gel aus dem natürlichen Zucker Desoxyribose bei Mäusen starkes Haarwachstum fördert, vergleichbar mit dem etablierten Mittel Minoxidil.

Ein neues KI-Modell von Meta namens V-JEPA lernt physikalische Gesetze wie Objektpermanenz, indem es Videos analysiert – ähnlich wie ein menschliches Baby.

Eine neue Studie zeigt, wie künstliche Intelligenz DNA für gefährliche Proteine so umschreiben kann, dass etablierte Biosicherheitssysteme sie nicht erkennen.

Die Raumsonde Voyager 1, gestartet 1977, wird am 15. November 2026 einen historischen Meilenstein erreichen: Sie wird einen Lichttag von der Erde entfernt sein.

Forscher an der University of Virginia haben eine neue Methode entwickelt, um winzige Roboter zu bauen, die sich wie Insekten auf dem Wasser bewegen können.

Ärzte in Boston behandelten eine 63-jährige Frau mit starken Bauchschmerzen, indem sie eine Magenmasse mit Diät-Cola auflösten. Der Fall steht im Zusammenhang mit einem Medikament zur Gewichtsabnahme.

Eine interne E-Mail am NASA Jet Propulsion Laboratory (JPL) kündigt eine Reorganisation und Entlassungen für Oktober 2025 an und sorgt für große Unruhe.